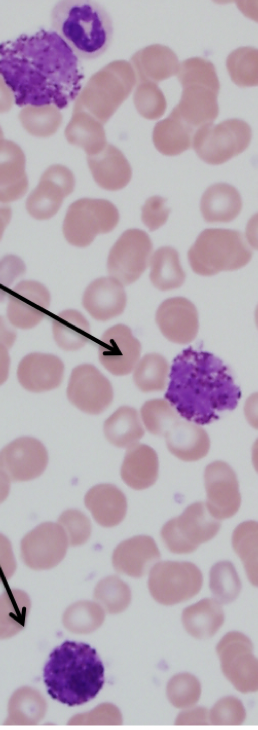

1
Q
what source?
what do you see?
diagnosis?

A
- peripheral blood
- numerous immature granulocytes
- CML
2
Q
what part of the body?
what do you see?
diagnosis?
A
- peripheral blood
- basophils
- CML
3
Q
what is the source?
what do you see?
diagnosis?

A
- bone marrow aspirate
- hypercellularity and increased M:E
- CML
4
Q
- where in the body?
- what do you see?
- diagnosis?

A
- bone marrow biopsy
- maturing granulocytes
- CML
5
Q
- what source
- what do you see?
- diagnosis

A
- bone marrow aspirate
- maturing granulocytes
- CML
6
Q
diagnosis?

A
- CLL
7
Q
diagnosis?

A
- CLL
8
Q
source?
what do you see?
diagnosis?

A
- peripheral blood
- lymphocytosis
- CLL
9
Q
source?
what do you see?
diagnosis?

A
- bone marrow aspirate
- variable involvement, loss of heterogeneity
- CLL
10
Q
what do you see?
diagnosis?

A
- Auer rods
- AML
11
Q
source?
what do you see?
diagnosis?

A
- bone marrow biopsy
- monotonous population of mononuclear cells
- AML
12
Q
what do you see?
diagnosis?

A
- lots of granules
- APL
13
Q
diagnosis?

A
- ALL
14
Q
what do you see?
diagnosis?

A
- large cells, open chromatin, prominent nucleoli
- ALL


